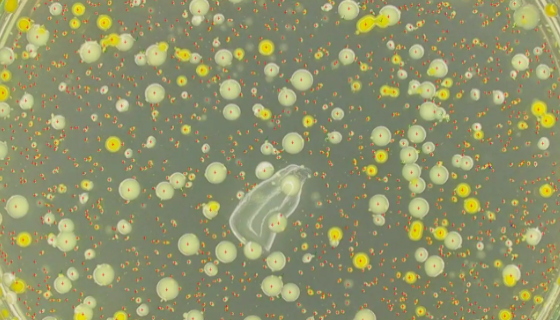
恶臭假单胞菌的临床意义与表现及微生物学检验！

恶臭假单胞菌的临床意义与表现及微生物学检验!
恶臭假单胞菌,革兰阴性杆菌,有些菌株为卵圆形,单端丛毛菌,运...

阴道阿波托菌的培养方法与使用范围及注意事项!
阴道阿波托菌的培养方法与使用范围及注意事项有哪些?

永生化人视网膜周细胞的处理方法与培养步骤!
人视网膜周细胞仅用于科学研究或者工业应用等非医疗目的不可用于...

UE7T-13人骨髓间充质干细胞复苏与传代及冻存操作说明!
人骨髓间充质干细胞分离自骨髓;骨髓是机体的造血组织,位于身体...

椭圆酿酒酵母的形态特征与培养方法及注意事项!
椭圆酿酒酵母是Saccharomyces属的微生物,原产地为...

MPASMC(小鼠肺动脉平滑肌细胞)的处理方法与培养步骤!
小鼠肺动脉平滑肌细胞的处理方法与培养步骤及注意事项有哪些?

Tca-83人口腔鳞癌细胞的培养方法与注意事项!
人口腔鳞癌细胞的处理方法与培养步骤及注意事项。

结核分歧杆菌的生物学性状与培养特性及生化反应!
结核分歧杆菌(M.tuberculosis),俗称结核杆菌,...

乳酸杆菌属的形态特征与培养方法及打管说明!
乳酸杆菌属是Lactobacillus属的微生物,原产地为中...